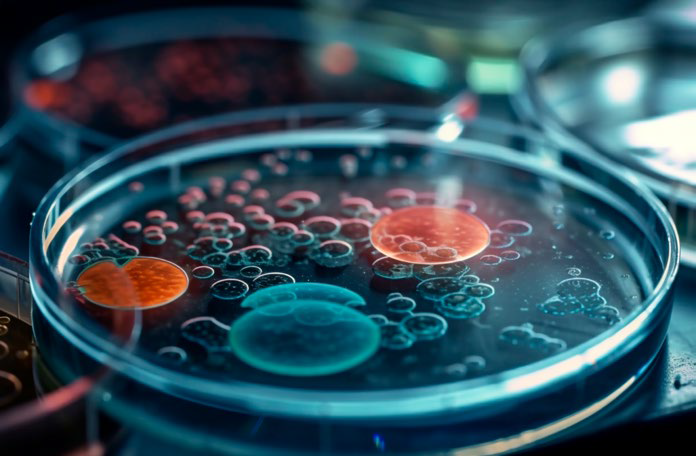

As warmer weather encourages outdoor activities, the risk of exposure to ticks—and consequently Lyme disease—also increases. Over the past 24 years, the incidence of Lyme disease has more than doubled, largely due to the rising populations of Ixodes ticks, commonly known as black-legged or deer ticks. This article provides veterinary professionals with essential insights into the impact of climate change on tick behavior and the transmission of Lyme disease.
Warmer Weather and Tick Activity
Temperature plays a crucial role in the life cycle and prevalence of Ixodes ticks. These ticks are most active when temperatures exceed 45°F (7°C). Climate change has led to milder winters and prolonged summers, extending the period during which ticks are active and increasing their chances of survival. This extension in activity poses a heightened risk for both humans and animals alike, making it essential for veterinarians to educate pet owners about tick prevention.
Expanding Range of Ticks
The impacts of climate change are not limited to temperature; they also affect humidity levels and the distribution of tick populations. Warmer and wetter conditions have allowed Ixodes ticks to expand their range into areas that were previously inhospitable, such as northern regions and higher altitudes. This expansion can lead to an increased risk of Lyme disease in previously unaffected areas, prompting the need for veterinarians to remain vigilant in monitoring tick populations and advising pet owners on preventive measures.
The Impact on Tick Hosts
Warming temperatures also influence the habitats of tick hosts, including rodents, birds, and deer. As these animals adapt to changing climates and expand their territories, they may carry ticks and the associated risk of Lyme disease into new areas. Veterinary professionals should be aware of the dynamics between host species and tick populations, as these relationships can significantly impact the prevalence of Lyme disease in domestic animals.
Understanding Lyme Disease
The U.S. Centers for Disease Control and Prevention (CDC) estimates that around 476,000 humans are diagnosed with Lyme disease annually. As cases continue to rise in various regions, veterinarians must understand the implications for animal health. Here are five key facts about Lyme disease that are especially relevant in the veterinary context:
Urban Risk: Lyme disease is not limited to rural environments. Ticks can inhabit urban areas with sufficient vegetation, making it possible for pets to contract Lyme disease during routine outdoor activities like walks or playtime in gardens.
Transmission Time: Ticks must generally remain attached for over 24 hours to transmit Lyme disease. Prompt removal of ticks significantly reduces the risk of transmission. Veterinary professionals should advise pet owners on proper tick removal techniques and recommend regular tick checks, especially in high-risk areas.
Potential Long-Term Complications: While early intervention can minimize the risk of Lyme disease, some animals may experience persistent symptoms after treatment. Veterinary professionals should be prepared to monitor and manage these cases to ensure full recovery and maintain the well-being of affected pets.
Global Presence: Lyme disease is increasingly recognized worldwide, with reported cases in various countries across the Americas, Europe, and Asia. Veterinary practitioners must stay informed about Lyme disease’s geographic distribution to advise pet owners accordingly, especially when traveling.
Reinfection Possibility: Animals previously diagnosed with Lyme disease can be reinfected. Currently, there are vaccines under development, but until they become available, preventive measures such as tick control products, regular checks, and educating pet owners remain critical strategies to protect pets from Lyme disease.
Conclusion
As climate change continues to influence tick populations and Lyme disease transmission, veterinary professionals play a vital role in educating pet owners about the associated risks and preventive strategies. By understanding the dynamics of ticks, their hosts, and the environmental factors that affect their behavior, veterinarians can better protect the health of both pets and their owners.

No comment